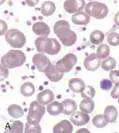
圖片

107年:(醫檢)血液(1)
一位 46 歲的男性病患,因脾臟腫大與不明原因的出血症狀來醫院檢查, CBC 檢查發現 RBC=4.7×10 12 /L 、WBC=15×10 9/L 、Platelet=650×10 9/L ;血液抹片如圖 ①(thrombocytosis with anisocytosis );骨髓抹片如圖②(低倍顯微鏡, megakaryocytes 增生現象)、圖 ③(高倍顯微鏡, megakaryocytes 廣泛分葉現象),則此病患最可能是下列何種疾病?

Ahairy cell leukemia
Bacute monoblastic leukemia
Cacute erythroid leukemia
Dessential thrombocythemia
詳細解析
本題觀念:
本題考查骨髓增殖性腫瘤(myeloproliferative neoplasm, MPN)的鑑別診斷,特別是**原發性血小板增多症(essential thrombocythemia, ET)**的特徵性血液學與骨髓形態表現。
影像分析:
圖①(血液抹片): 血液抹片呈現大量血小板(thrombocytosis),並可見紅血球大小不均(anisocytosis)。視野中可見多量小型紫色顆粒狀的血小板聚集於紅血球之間,白血球形態相對正常。此抹片特徵與骨髓增殖性疾病造成的反應性血小板增多一致。
圖②(骨髓抹片,低倍顯微鏡): 低倍視野下可見骨髓細胞性正常至稍微增加,最顯著的特徵是大型多核細胞(巨核細胞,megakaryocytes)的數量明顯增多,並可見其散在或鬆散群聚分布。骨髓整體形態顯示增生活躍但無明顯纖維化改變,此為 ET 骨髓形態的典型表現。
圖③(骨髓抹片,高倍顯微鏡): 高倍視野下可清晰見到多個大型的 megakaryocytes,其細胞核呈現廣泛分葉(hyperlobulated nuclei),形如「鹿角狀(staghorn-like)」分葉。細胞質豐富,整體細胞形態成熟。此種 megakaryocytes 廣泛分葉現象是 ET 最具代表性的骨髓病理特徵,有別於原發性骨髓纖維化(primary myelofibr
...(解析預覽)...

升級 VIP 解鎖圖文解析